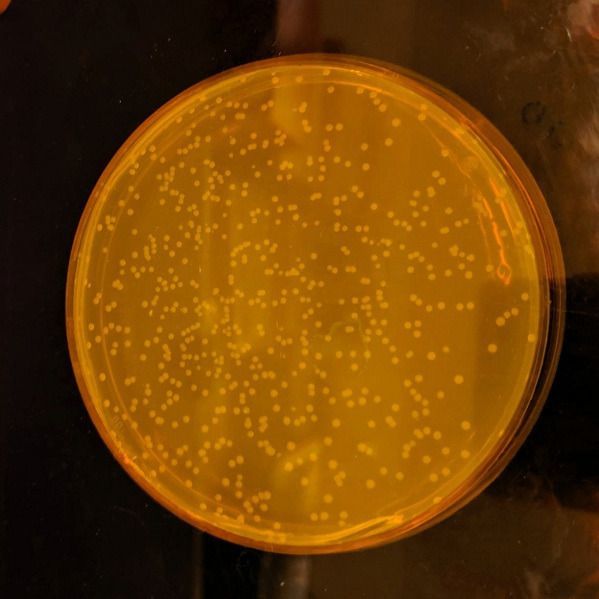

Columnistas
La Natividad de Syn61, el adviento que por fortuna nos tocó
Opinión
Por: Luis Orlando Ávila Hernández
Para diciembre de 2018 en un frio salón de Cambridge, todos le esperaban, esperábamos, con anhelo y con el ansia de lo nunca alcanzado: el nacimiento, el adviento, su promesa.
Su llegada, su espontaneo crecimiento, anunciaba una nueva esperanza para la raza humana: la cristiana, la musulmana, la judía histórica, la payasada judía del evangelismo-protestantismo (a la colombiana, a lo Miami), la budista, la animista, la rastafari, la hinduista y por supuesto la infaltable pacha-mama.
El adviento tan ansiado el pasado diciembre, propicia una luz a la diabetes, a los infartos, a las enfermedades crónicas heredadas, a la tragedia humana de la imperfección, del error codificado: al inicio del fin del juego de los dados de Dios.
La paradoja, como en todo lo bueno, es que lo recién nacido, lo advenedizo, nacía precisamente del pecado del desecho, de lo impronunciable, para bien de todos: hijos y no hijos de Dios o de los Dioses.
Mas su nacimiento fue una fortuna para la humanidad, el pasado diciembre de 2018.
Lo que pasa es que el cotidiano ruido de nuestras guerras, de nuestros rutinarios consumos, de nuestros imprescindibles deseos (re) programados, de nuestra necesaria alienación auto infligida, de nuestra exigida frustración mañanera, no nos dejó apreciar el hermoso cuadro de su llegada casi sacra, como nuestro único camino a la salvación como especie.
A diferencia del venerado retablo inventado por los curas franciscanos, para retar mediante la parla al entonces poder Borbón de la corona española de mediados del siglo XVI, tergiversando una vez más en su tara monoteísta la historia a su burdo acomodo de su único Dios, el adviento del pasado diciembre de 2018, si contó con la presencia y evidencia tipo APA 6ª Ed., de por lo menos una docena de monoteístas, politeístas, ateos, agnósticos: JuliusFredens, Kaihang Wang, Daniel de la Torre, Louise F. H. Funke, Wesley E. Robertson, YonkaChristova, TiongsunChia, Wolfgang H. Schmied, Daniel L. Dunkelmann, VáclavBeránek, ChayasithUttamapinant, AndresGonzalez Llamazares, Thomas S. Elliotty Jason W. Chin.
La mención al adviento de diciembre pasado en Cambridge, aunque no tan literario como en los evangelios del Nuevo Testamento, de la Torah, del Corán, del Popol Vuh, del Majabhárata y sus versiones, del Bodhidharma, del Caritas Cristi UrgetNos, de los Sutras, entre los muchos que pudiera la superstición universal publicar, es más bien sencillo:
“Síntesis total de Escherichiacoli con un genoma recodificado”, Revista Nature mayo 15 de 2019.
Por primera vez la mente humana, crea el primer organismo o ser vivo que nace y se reproduce con todas sus partes hechas en laboratorio.
Dirán los hijos, hijas e hijes de los creyentes, que es obra divina o por lo menos de la ingeniería divina.
Que lo digan.
Es lo suyo: especular, para luego rezar u orar, para volver a especular. Es la historia del dominio y la abyección.
Lo cierto es que desde 2010, no se sabía de un avance científico tan importante camino a eliminar la imperfección (dolor y muerte) de la enfermedad, o por lo menos de tratarla, evitándola, al alterar su designio de muerte trágica.
El cáncer, la evidencia de la inexistencia de Dios o de los Dioses y de la consecuente estafa de sus gerentes humanos (pastores, curas, rabinos, brahmanes, monjes, rastas, sacerdotes o chamanes), va camino a su eliminación de la faz de esta Tierra, gracias al nacimiento de la mesiánica Escherichiacoli Syn61, la pobladora predilecta y ultra necesaria de nuestras tripas y de lo que desde éstas, se excreta a diario.
El proceso fue sencillo, o por lo menos así nos lo hace ver el diario británico TheGuardian, hoy 15 de mayo que sale la noticia acerca de la estrella que alumbró el cielo de la Universidad de Cambridge la noche del 18 de diciembre de 2018:
“…’Es bastante sorprendente’, dijo Chin (uno de los científicos, Jason W. Chin). Cuando se creó el microbio, poco antes de Navidad, el equipo de investigación se tomó una foto en el laboratorio con una placa de los microbios como la figura central en una recreación de la natividad.”
“…Durante un esfuerzo de dos años, los investigadores del laboratorio de biología molecular de la Universidad de Cambridge leyeron y rediseñaron el ADN de la bacteria Escherichiacoli (E coli), antes de crear células con una versión sintética del genoma alterado.El genoma artificial contiene 4millones de pares de bases, las unidades del código genético enunciadas por las letras G, A, T y C. Las cuales para tener una comparación, por ejemplo, al ser impresas en su totalidad en hojas oficio (A4), llenan en total 970 páginas, lo que hace que el genoma sea el más grande que los científicos, jamás hayan construido.”
“…El ADN enrollado dentro de una célula contiene las instrucciones que necesita para funcionar. Cuando la célula necesita más proteínas para crecer, por ejemplo, lee el ADN que codifica la proteína correcta. Las letras de ADN se leen en tríos llamados codones, como TCG y TCA.Casi toda en la vida, desde las medusas hasta los humanos, utiliza 64 codones. Pero muchos de ellos hacen el mismo trabajo. En total, 61 codones producen 20 aminoácidos naturales, que se pueden unir como cuentas en una cuerda para construir cualquier proteína en la naturaleza. Hay tres codones más que son señales de suspensión del efecto: le dicen a la célula cuando la proteína está lista, como la llamada que marca el final de esta oración.”
“…La industria biofarmacéutica ya utiliza E. colipara fabricar insulina para la diabetes y otros compuestos médicos para el cáncer, esclerosis múltiple, ataques cardíacos y enfermedades oculares, pero la producción completa puede verse afectada cuando los cultivos bacterianos están contaminados con virus u otros microbios. Sin embargo eso no es todo: en un trabajo futuro, el código genético liberado podría ser reutilizado para hacer que las células produzcan enzimas, proteínas y medicamentos de diseño.”
Finalmente la gran noticia ante el adviento científico, según informa TheGuardian, es que el record de E. colipuede no durar mucho, Tom Ellis junto a otros científicos, un investigador de biología sintética del Imperial College London, están construyendo un genoma sintético para la levadura del pan, mientras que los científicos de Harvard están haciendo genomas bacterianos, con más cambios de codificación.
El hecho de que la E. coli Syn61 rediseñada, no crezca tan bien como lo hace en sus cepas naturales, no es sorprendente, agregó Ellis. "Si hay algo sorprendente, es que crece después de tantos cambios", dijo.
De esta manera, JuliusFredens, Kaihang Wang, Daniel de la Torre, Louise F. H. Funke, Wesley E. Robertson, YonkaChristova, TiongsunChia, Wolfgang H. Schmied, Daniel L. Dunkelmann, VáclavBeránek, ChayasithUttamapinant, AndrésGonzález Llamazares, Thomas S. Elliotty Jason W. Chin, junto a muchos más científicos de biología sintética, quienes conjuntamente crearon la E. coli Syn61 sintética y alterada genéticamente, bien pudieran ser las figuras iconos que adornaran el futuro pesebre de la segunda mitad del siglo XXI, cuando hayan pasado muchos años que tras morirnos con los más dolorosos cánceres, cantábamos villancicos, orábamos, rezábamos y votábamos al Centro Democrático, defecando millones de bacterias de Escherichiacoli sin más utilidad que nuestra fétida creencia.























(CO) 313 381 6244
(CO) 311 228 8185
(CO) 313 829 8771